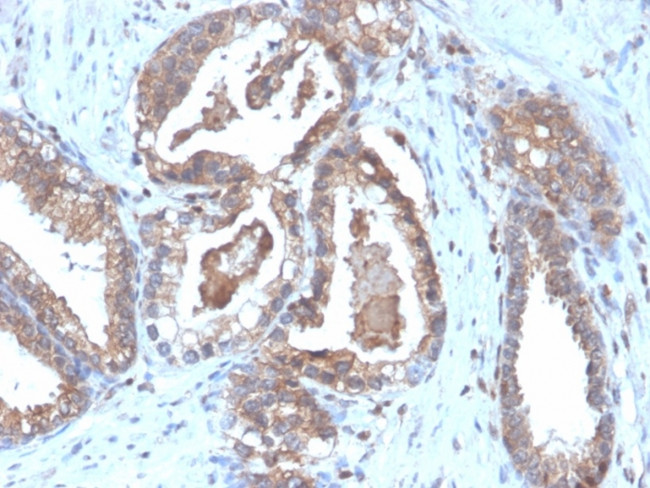
CD47/IAP (Integrin Associated Protein) Antibody in Immunohistochemistry (Paraffin) (IHC (P))

Search
NeoBiotechnologies
CD47/IAP (Integrin Associated Protein) Recombinant Rabbit Monoclonal Antibody (CD47, 6364R)
{{$productOrderCtrl.translations['antibody.pdp.commerceCard.promotion.promotions']}}
{{$productOrderCtrl.translations['antibody.pdp.commerceCard.promotion.viewpromo']}}
{{$productOrderCtrl.translations['antibody.pdp.commerceCard.promotion.promocode']}}: {{promo.promoCode}} {{promo.promoTitle}} {{promo.promoDescription}}. {{$productOrderCtrl.translations['antibody.pdp.commerceCard.promotion.learnmore']}}
图: 1 / 2
CD47/IAP (Integrin Associated Protein) Antibody (961-RBM14-P1ABX) in IHC (P)


产品信息
961-RBM14-P1ABX
种属反应
宿主/亚型
Expression System
分类
类型
克隆号
抗原
偶联物
形式
浓度
规格
纯化类型
保存液
内含物
保存条件
运输条件
产品详细信息
Immunohistochemistry (PFA fixed): incubate antibody for 30 min RT. Staining of formalin-fixed tissues requires heating tissue sections in 10mM Tris with 1mM EDTA, pH 9.0, for 45 min at 95 degrees C followed by cooling at RT for 20 minutes.
靶标信息
CD47, known as integrin-associated protein (IAP), is a glycosylated transmembrane glycoprotein with five domains, expressed widely across hematopoietic cells like T and B cells, monocytes, platelets, and erythrocytes, as well as non-hematopoietic cells. It interacts with integrins such as CD51/CD61 and CD41/CD61, and serves as a receptor for thrombospondin, mediating bi-directional signaling that affects neural synaptic activity and macrophage phagocytosis. CD47 acts as a ligand for CD172a (SIRP alpha), an inhibitory receptor on macrophages, preventing phagocytosis of CD47-positive cells. This interaction influences cell migration, B cell adhesion, T cell activation, and neuronal development, particularly in synapse-rich brain and retina regions. It also modulates chondrocyte responses to mechanical signals. T cell expression of CD47 can lead to activation or apoptosis in the presence of thrombospondin. Monoclonal antibody stimulation of CD47 has been shown to induce CD4+CD25- suppressive activity and increase Foxp3 expression. CD47's role in membrane transport, signal transduction, and its broad tissue distribution highlight its significance in various physiological processes.
仅用于科研。不用于诊断过程。未经明确授权不得转售。
篇参考文献 (0)
生物信息学
蛋白别名: antigen identified by monoclonal antibody 1D8; Antigenic surface determinant protein OA3; CD47; CD47 antigen; CD47 antigen (Rh-related antigen, integrin-associated signal transducer); CD47 glycoprotein; IAP; integrin associated protein; Integrin-associated protein; integrin-associated signal transducer; Leukocyte surface antigen CD47; Protein MER6; Rh-related antigen; sCD47; soluble CD 47; soluble CD47; unnamed protein product
基因别名: CD47; IAP; MER6; OA3
UniProt ID: (Human) Q08722
Entrez Gene ID: (Human) 961